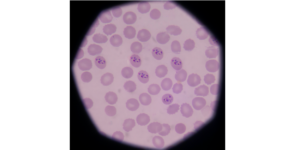

PEST PULSE: MOSQUITO SURVEY
How much mosquito work do you do in your part of the country? In our Pest Pulse survey, we asked readers to tell us.
For many mosquitoes are an annoyance, ruining outdoor entertaining. However, even in Australian, there is the risk of picking up a mosquito borne disease as a result of mosquito bites.
One of the best mosquito treatments for residential and commercial properties is to spray the mosquito resting areas surrounding the building and outdoor areas with insecticide. This can create a mosquito interception zone which can significantly reduce mosquito numbers for up to 3 months.
For water bodies than can be eliminated, treatment with insect growth regulators to prevent the development of larvae can be a very effective method of mosquito population control. Learn more about treating mosquito breeding sites.
Homeowners can reduce mosquito problems around their home by eliminating mosquito breeding sites. Learn more about mosquito prevention tips.
Mosquito repellents are an important tool to prevent mosquito bites, especially when out and about. DEET is one of the recommended repellents. Researchers have made some new discoveries on how DEET works.
Although not common, there are a range of mosquito borne diseases in Australia. Dengue fever is confined to the tropical north with occasional outbreaks.
There are also outbreaks of Ross River fever, Murray Valley encephalitis and Japanese encephalitis.
There are also occasional outbreaks of the bairnsdale ulcer in Australia (called the buruli ulcer overseas), a skin condition, which is thought to be spread by mosquitoes.
Given the importance of mosquito control in preventing disease transmission globally, there is a lot of research on mosquito behaviour. One question people always ask is how far can mosquitoes fly? Which is very important when trying to set up a control program.
Similarly in developing new mosquito repellents, it’s important to know how mosquitoes find their host.
More information on mosquitoes.
How much mosquito work do you do in your part of the country? In our Pest Pulse survey, we asked readers to tell us.

Helpful tips on how to deliver mosquito treatments with the greatest chance of success for your customers.

Are mosquitoes to blame for the increase in Buruli ulcer outbreaks?

Townsville has become home to a modified population of mosquitoes in a measure to curb outbreaks of dengue in the country.
The latest efforts in the war against mosquitoes seek to turn them against themselves by manipulating their genetic makeup.

IGRs, such as Sumilarv G from Sumitomo, are an effective tool in the war on mosquitoes and fleas, targeting larvae as they moult.

A spray insecticide such as Bithor from Ensystex is an effective tool for creating a mosquito protection zone in areas of high mosquito pressure.

Australia has an interesting history when it comes to dengue fever.

Featuring an insect growth regulator, Sumilarv G is an effective way to control mosquitoes and flies.

Dr Mark Walker from FMC’s Specialty Solutions team shares his tips on how to combat mosquitoes, with advice for ensuring the most effective application of insecticides.

Gaining control of mosquitoes requires a targeted approach using complementary modes of action, explains Steve Broadbent, regional director of Ensystex.

As part of its wider vector control program, Bayer is investing resources in attempting to halt the global spread of Zika virus.